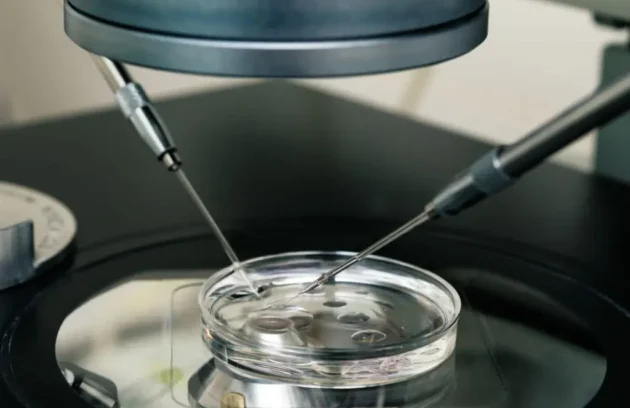

EMMA, ALICE ed Endometriome sono test avanzati per lo studio del microbiota endometriale. Utili nei casi di infertilità, fallimenti d’impianto…
- 13 Luglio 2025
Fecondazione in Vitro
- 13 Luglio 2025
Crioconservazione (Embrioni e Gameti)
- 8 Luglio 2025
Controlli di qualità
- 29 Giugno 2025
Analisi KIR e HLA-C
- 15 Giugno 2025